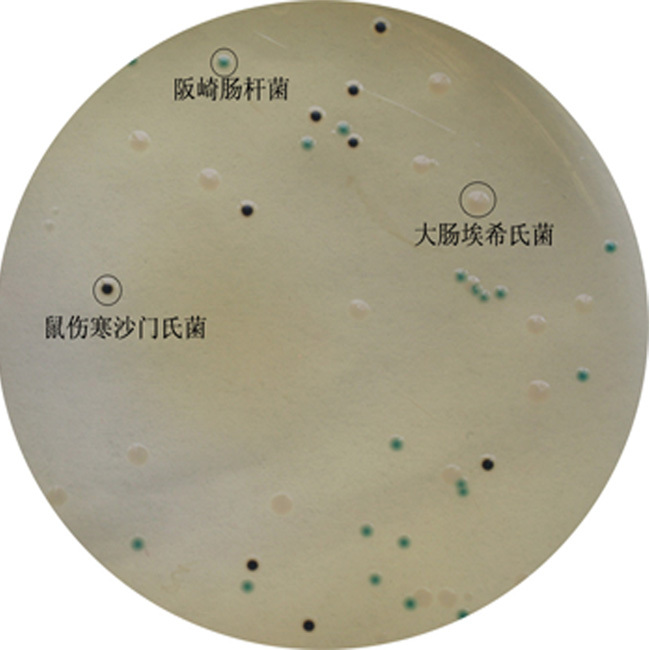
阪崎肠杆菌显色平板(dfi琼脂)(9cm)

大肠杆菌平板

大肠杆菌平板培养计数
图片尺寸2976x3968
"因为他发现他昨晚连接平板上除了自己涂布的大肠杆菌,还有一行颜色
图片尺寸600x450
这是平板接种大肠杆菌24小时之后观察到的现象.
图片尺寸2667x2000
大肠杆菌o157筛选显色平板 9cm 初筛分离培养 大肠菌群 10个装
图片尺寸350x350
crm002a大肠杆菌显色培养基平板90mm
图片尺寸514x497
为什么我培养出的大肠杆菌有大有小有uu们知道是不纯吗
图片尺寸1080x810
emb平板上大肠杆菌菌落表面有金属光泽
图片尺寸1600x1200
法国科玛嘉 o157显色平板 用于临床和食品中大肠杆菌0157的检测
图片尺寸800x800
生长抑制试验:将不同的材料和大肠杆菌菌液孵育后涂在lb琼脂平板上.
图片尺寸1000x992
emb 大肠杆菌.jpg
图片尺寸737x672
大肠杆菌的稀释平板计数老是出不来菌落求助各位大神
图片尺寸900x675
麦康凯培养基上的细菌菌落特征: 大肠埃希氏菌atcc25922 福氏志贺氏
图片尺寸400x400
大家帮分析大肠菌群平板结果(见图片)
图片尺寸3456x4608
谁能帮我判断一下,emb 平板上这是大肠杆菌典型菌落吗?
图片尺寸1080x1920
阪崎肠杆菌显色平板(dfi琼脂)(9cm)
图片尺寸650x650
大家帮分析大肠菌群平板结果(见图片)
图片尺寸3456x4608
大家帮分析大肠菌群平板结果(见图片)
图片尺寸3456x4608
ecc显色琼脂平板ecc显色培养基大肠菌群大肠杆菌ecc显色培养基平板
图片尺寸412x402
山梨醇麦康凯琼脂平板
图片尺寸499x500
emb 大肠埃希氏菌atcc25922emb 大肠埃希氏菌atcc8739emb 大肠埃希氏
图片尺寸400x400